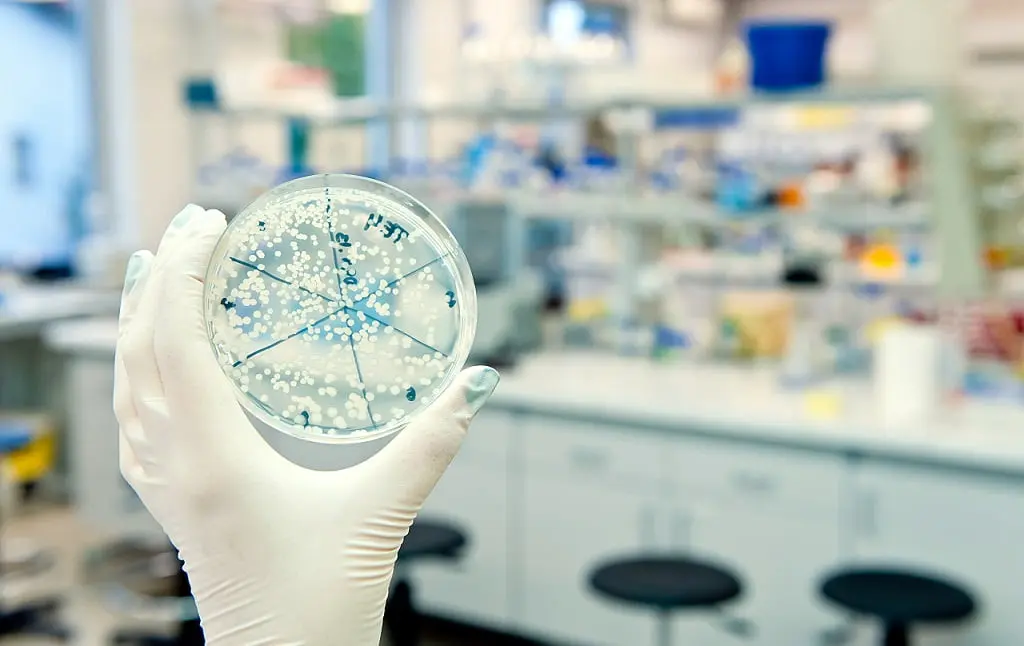

微生物检测项目计量单位:CFU 与 MPN 的差异比较
发布时间:2025-12-26 浏览次数:18235
CFU 与 MPN 有什么不一样? 微生物计量单位
进行微生物品管检测时,常以细菌数目的多少,搭配法规标准作为质量判断的依据,进而决定该批产品是否合格。但进行了这么多次品管计划,阅读了这么多份检验报告,您是否注意过微生物的数据呈现有 CFU 与 MPN 两个不同的单位呢?这两个单位分别代表什么意义呢?
CFU 是菌落形成单位
CFU 是菌落形成单位 (Colony-forming unit) 的缩写,是指样品在适当的稀释状态下,每一个细菌细胞在培养基上,生长繁殖所形成的单一易区别菌落,每菌落单位称为 1 CFU。
CFU/g :每公克样品中含有的细菌菌落总数。
CFU/mL:每毫升样品中含有的细菌菌落总数。
CFU/cm2:每平方公分样品中含有的细菌菌落总数。
此计算方式便于判别产品卫生状况或微生物污染程度,数字越大表示样品中微生物含量越多,数字越小表示越少微生物存在。然而还是有所缺点,一方面样品中的细菌可能因处理时受到伤害死亡,一方面因微生物本身对于氧气、温度、营养等生存条件的需求差异,在培养条件下无法生长形成菌落,不过这些死亡或无法生长的细菌并非我们主要的实验标的或不会影响测试目的,因此并不会显著影响实验结果所呈现的意义。

培养基上每个菌落形成单位 (Colony-forming unit)
MPN 是最大可能数
MPN 是最大可能数 (Most probable number) 的缩写,又称稀释培养计数法,结合微生物学与统计学的检测数值表示法,数字并非实际细菌数目,而是通过统计模型,推算实际菌数最可能落在信赖区间的位置,即该样品最可能有多少细菌的估测值。
相较于 CFU 方法直接计算培养出来的真实菌落数,MPN 法必须将样品备制成 3 个连续 10 倍稀释的系列稀释液,每稀释系列进行 3 次重复的液体培养基的接种培养(注一),即所谓的“三阶 3 支”稀释培养法,通过培养后观察到的微生物生长正反应数目,去比对 MPN 表(最大可能数表)查出该微生物最大机率的可能数目,最终检验结果以样品的每单位重量或容量所含 MPN 数,即以 MPN/g 或 MPN/mL 为单位表示之。
MPN 的缺点除为估计值外,操作步骤繁琐复杂,从培养基的配置、细菌的转移接种、正反应的判定、MPN 数值的换算,甚至更有部分目标细菌须搭配菌种鉴定来确认实验结果,较耗时费力。
注一、视实验方法不同,每个稀释系列可能会做到 5 次重复的液体培养基的接种培养,即“三阶 5 支”。
最大可能数 (Most probable number) 法简易流程图

CFU 和 MPN 的差别比较
CFU 单位是建立在以平板固态培养基滋长细菌后,实际统计的真实菌落数。
MPN 单位则是观察发酵管中的液态培养基细菌滋长情形,然后以统计学推估的最可能细菌数目。
两者依据不同的实验方法、不同的统计基础下,呈现不同的微生物数量表示单位,虽然两者有所差异,但从《食品安全国家标准管理办法》的指标菌及致病菌检验方法可以看到,不同的微生物检测项目可能以不同单位表示,端看实验进行方式,并无优劣与否、孰者为先的问题。
单位表示 | 菌落形成单位 (CFU) | 最大可能数 (MPN) |
实验方法说明 | 以倾注法或涂抹法在平板固态培养基滋长细菌,实际统计真实菌落数 | 观察发酵管中的液态培养基细菌滋长情形,然后以统计学推估最可能的细菌数 |
实验方法比较 | 实验步骤较简便 | 实验步骤复杂 |
数据判读说明 | 预设每颗菌落皆由单一细菌繁殖形成,直接计数平板上的菌落数来推论菌数 | 样品可使用范围较大,可用于不可过滤之样品。以「三阶 3 支」稀释培养之微生物生长正反应数目,比对 MPN 表(最大可能数表)查出微生物最可能数目 |
数据判读比较 | CFU 为真实数值 | MPN 为统计推估值 |










